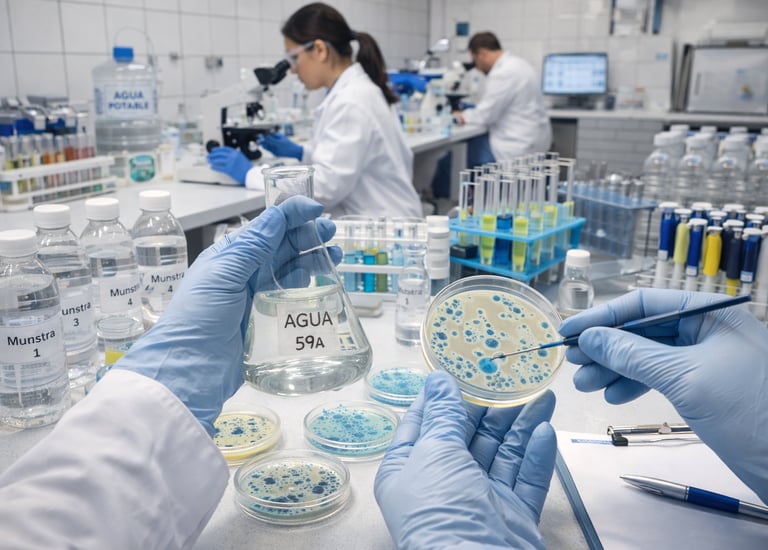

Comprometidos con la Seguridad Alimentaria
En Esal Seguridad Alimentaria, ayudamos a que tu negocio cumpla con todas las normativas y garantice alimentos seguros para todos.
150+
+100
Clientes satisfechos
Confianza real
a través de WhatsApp
Análisis
Realizamos todo tipo de análisis microbiológicos y físico químicos, en nuestro laboratorio asociado con acreditación ENAC 17025


Análisis Físico Químicos
Caracterización
Suelos
Aguas
Plaguicidas
Nutricionales
Análisis Microbiológicos
Análisis de aguas (continentales, aguas de riego, potabilidad)
Análisis de alimentos (industria hortofrutícola, cárnica, pastelería, pescado, comidas preparadas.etc)
Análisis de legionella (ACS, AFS)
Vida útil
Análisis
Solicita el análisis y perfil analítico que necesites

Análisis Agua
Análisis de potabilidad, análisis de aguas continentales, aguas de riego, legionella


Análisis Alimentos
Análisis microbiológicos y físico químicos de alimentos
Contacto
Escríbenos para asesorarte en Seguridad Alimentaria y análisis de alimentos.
